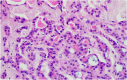

Atypical Femur Fracture Unmasking Follicular Thyroid Cancer in a 54-year-old Woman
- PMID: 38045799
- PMCID: PMC10690400
- DOI: 10.1016/j.aace.2023.07.005
Atypical Femur Fracture Unmasking Follicular Thyroid Cancer in a 54-year-old Woman
Conflict of interest statement
The authors have no multiplicity of interest to disclose. Patient consent was obtained. The views expressed in this article are those of the authors and do not reflect the official policy of the Department of Army/Navy/Air Force, Department of Defense, or the U.S. Government.
Figures

References
-
- Ashorobi D., Lopez P.P. StatPearls Publishing; 2023. Follicular Thyroid Cancer. - PubMed
LinkOut - more resources
Full Text Sources
